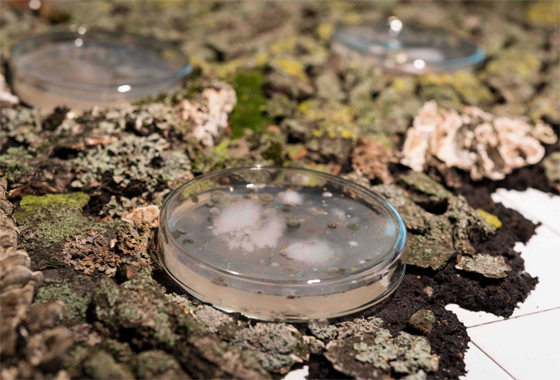

В Музее истории ГУЛАГа пройдет выставка «Лаборатории городской фауны»
В Музее истории ГУЛАГа пройдет выставка «Лаборатории городской фауны»
© «Лаборатория городской фауны» / V-A-C Foundation
© «Лаборатория городской фауны» / V-A-C Foundation C 18 января по 12 марта в Государственном музее истории ГУЛАГа в Москве группа художников «Лаборатория городской фауны» (Алексей Булдаков и Анастасия Потёмкина) представит в программе «Процессы. Опыты искусства в музее» проект «Новые лидеры регионального развития» (2014).
Проект демонстрирует экономический потенциал территорий, переданных в советские годы тюремно-лагерной системе.
На выставке среди прочего будет представлена новая серия акварельных работ коллектива и майнер-кинетическая скульптура. В основе такой скульптуры лежит использование энергетических отходов, остающихся от работы компьютерных серверов технологии блокчейн, которая часто применяется для добычи («майнинга») криптовалюты.
Кроме того, в рамках тематического блога «Ландшафт» состоится лекция Дэвида Гиссена о его проекте «Вандомская насыпь» (2012 — по настоящее время), будет подготовлен третий выпуск газеты и организована серия лекций директора Музея истории ГУЛАГа Романа Романова, исследователя и архитектора Франческо Себрегонди и доктора Шелы Шейх (Колледж Голдсмитс, Лондонский университет).
Программу «Процессы. Опыты искусства в музее» организуют фонд V-A-C и Музей истории ГУЛАГа. Она задумана в надежде на то, что искусство и инкорпорированные в него теоретическое и практическое знание могут сделать память о политических репрессиях продуктивной, стимулировать общественную дискуссию на эту тему, и, возможно, стать основой для постоянно действующей художественной и теоретической платформы.
Программа включает в себя ряд показов художественных работ, связанные с ними дискуссии, цикл встреч с художниками, историками и теоретиками, а также издание нескольких выпусков газеты. Первым проектом программы стала выставка Михаила Толмачева «Пакт молчания».